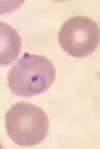

A malária é causada por 4 espécies de Plasmódio:
P. falciparum
P. malariae
P. vivax
P. ovale
Quem é e o que causa o Plasmodium falciparum?
Febre terçã maligna (19%)
> África
Quem é e o que causa o Plasmodium malariae?
Raros no BR (1%)
Causam febre quartã
Quem é e o que causa o Plasmodium vivax?
Espécie prevalente no BR (80%)
Causa a Febre terçã benigna
Quem é e o que causa o Plasmodium ovale?
Encontrada apenas em países africanos
Febre terçã benigna
Qual a espécie que mais causa malária no BR?
Plasmodium vivax
Qual é o nome do mosquito vetor da malária?
mosquito Anopheles
Quais as formas evolutivas do Plasmodium?
Esporozoítos
Trofozoítos
Esquizontes
Merozoítos
Quando o inseto vetor pica o homem, ele inocula qual forma evolutiva?
Ele injeta esporozoítos
O que acontece depois que o Anopheles inocula esporozoítos no organismo humano?
Eles infectam os hepatócitos, diferenciando-se em trofozoítos pré-eritrocíticos
Os trofozoítos se multiplicam no fígado e depois se transformam em que?
Em esquizontes teciduais
Quando os esquizontes teciduais se rompem, que forma eles liberam?
Merozoítos
Que tipo de célula os merozoítos invadem?
As hemácias/eritrócitos
Dentro das hemácias, os merozoítos se transformam em?
Esquizontes sanguíneos
Qual forma que causa a hemólise de hemácias?
Esquizontes sanguíneos
O rompimento das hemácias libera qual forma para o sangue?
Merozoítos
O que é a repetição do ciclo eritrocítico?
É quando as hemácias rompidas por esquizontes liberam merozoítos que irão infectar novas hemácias
Após alguns ciclos eritrocíticos, ocorre a diferenciação em estágios sexuados, chamados de:
gametócitos
Quando a fêmea Anopheles se alimenta do sangue, ela ingere:
os gametócitos
No interior do mosquito, os gametócitos se transformam em gametas, onde ocorre a fertilização e formação do ____ no intestino e depois _____ no estômago:
zigoto no intestino
e oocisto no estomago
O zigoto adquire mobilidade e começa a se movimentar, atravessando a matriz peritrófica, atingindo a parede do intestino médio do mosquito, onde irá se encistar e receberá o nome
OOCISTO
DENTRO DO MOSQUITO
Gameta ➙ zigoto ➙ oocineto ➙oocisto ➙ ?
esporozoítos
Quando o Anopheles pica o homem, qual forma ele injeta ?
esporozoítos
O P. falciparum invade qual tipo de hemácia?
Todas